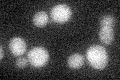
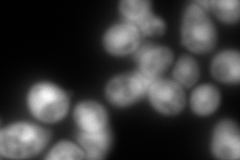
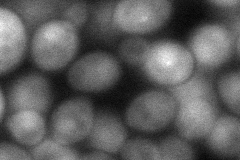

View description
Short-lived chaperone required for correct maturation of the 20S proteasome; may inhibit premature dimerization of proteasome half-mers; degraded by proteasome upon completion of its assembly
Localization:
Intensity:
Fold change:
Significance:
-
C’ GFP library in SD
below threshold17.96 -
N' NOP1pr-GFP in SD

cytosol,nucleus180.251 -
N' TEF2pr-mCherry in SD
cytosol,nucleusN/A -
N' NATIVEpr-GFP in SD

below threshold18.4954 -
N' TEF2pr-VC and Cyto-VN in SD
cytosol,nucleus64.6659 -
C’ GFP library in SD+DTT

cytosol15.920.88No -
C’ GFP library in SD+H2O2

cytosol15.060.83No -
C’ GFP library in Starvation Media

cytosol15.170.84No -
C’ GFP library on the background of Pup2-DaMP

below threshold -
C’ GFP library on the background of CCT mutant

below threshold16.68120.92842No
